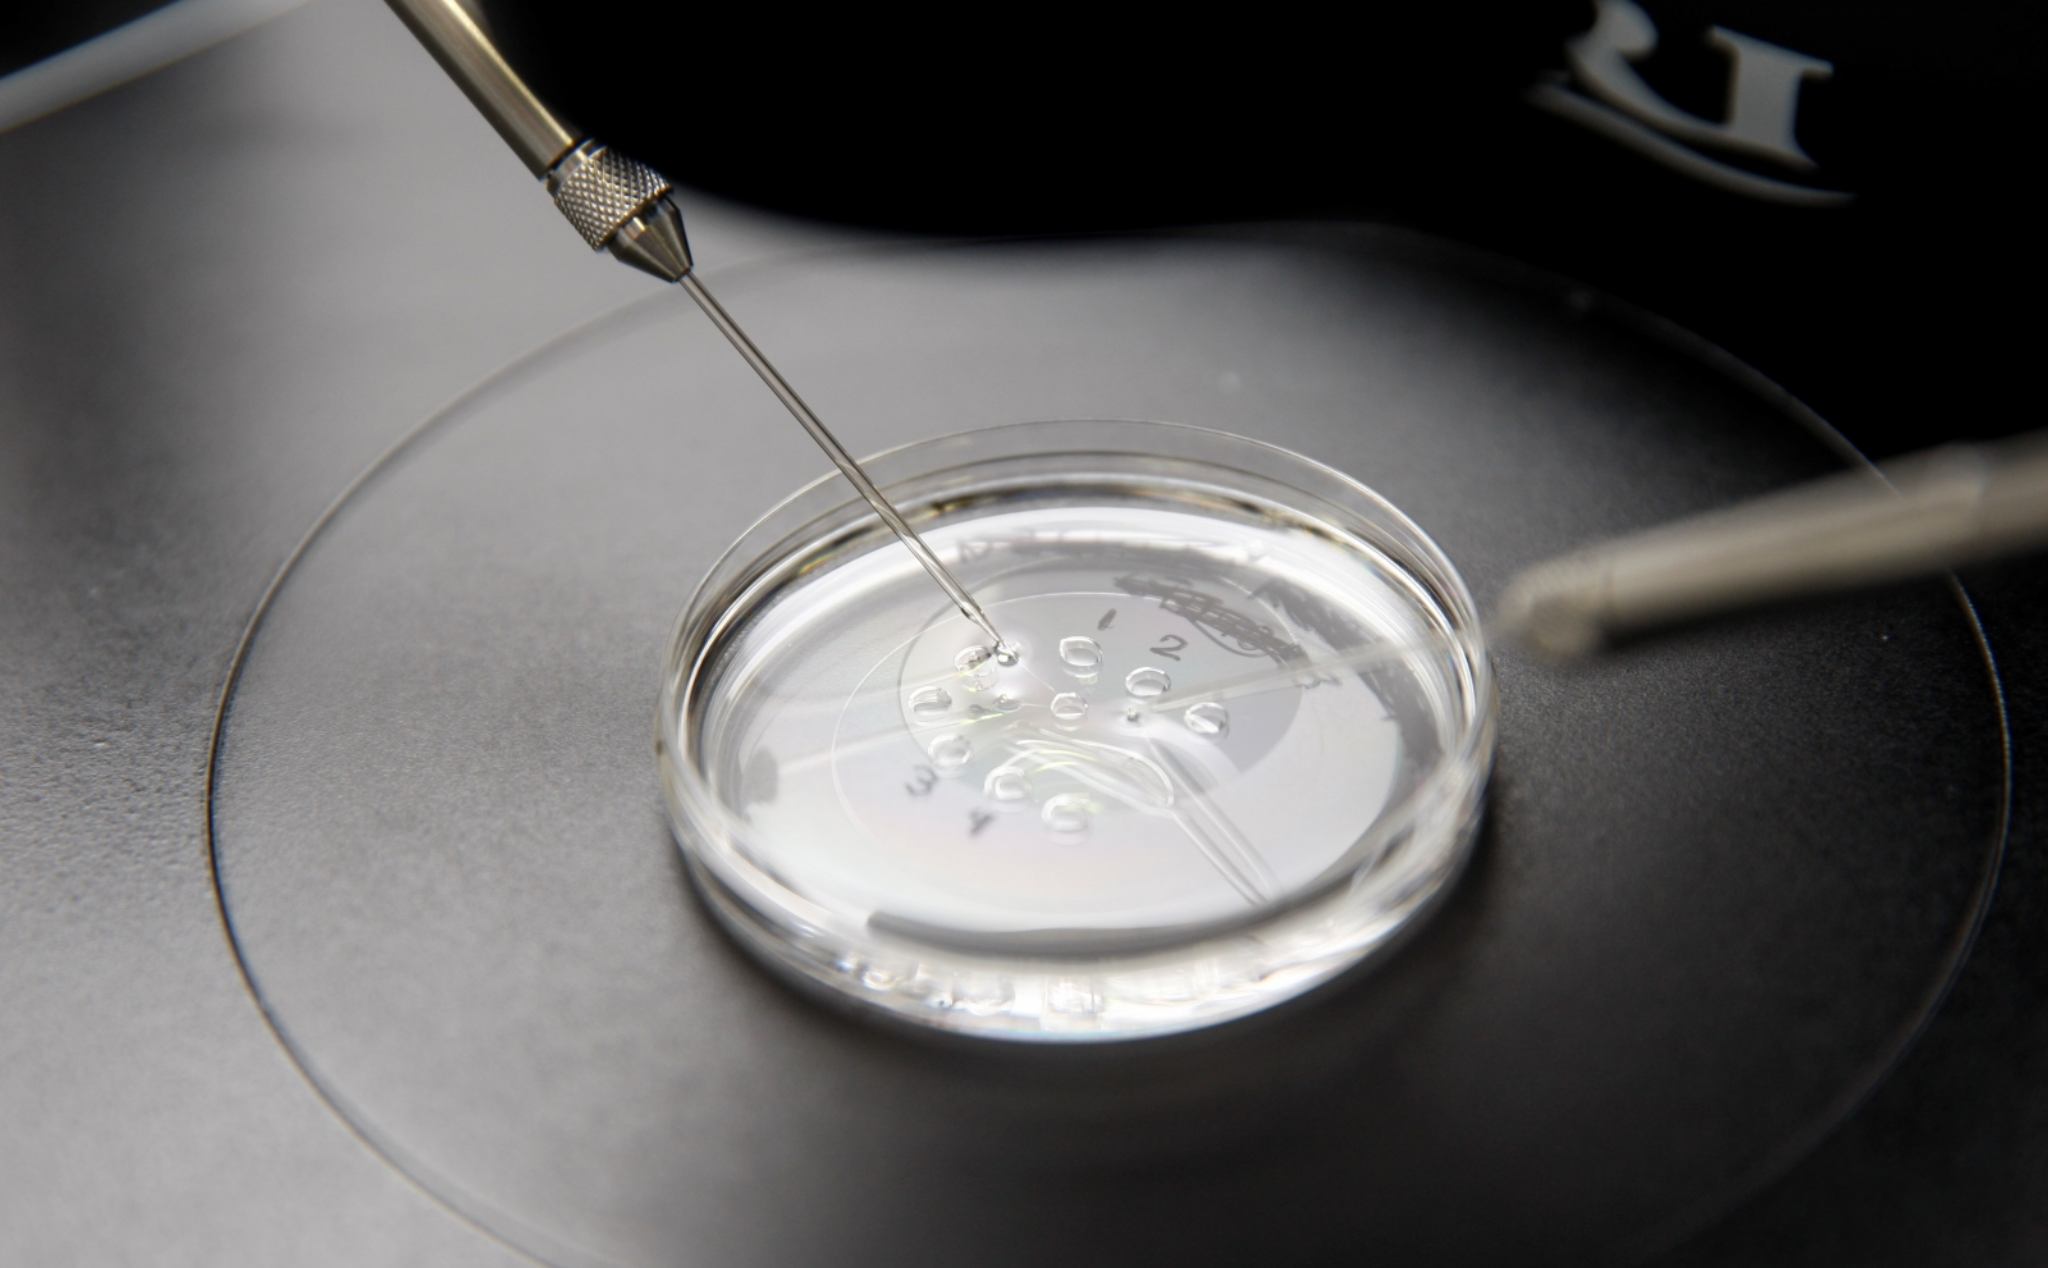

Sắp sửa tạo được tinh trùng và trứng ở trong phòng thí nghiệm
Được biết trước đó nhóm đã thành công tạo ra con chuột con từ tế bào của 2 con chuột đực. Vậy nên việc tạo ra trứng và tinh trùng như thế này có thể giải quyết được vấn đề về giảm tỷ lệ sinh trên toàn cầu mà không phải lo người bố/người mẹ/bạn đời?? có vấn đề gì về sinh sản hay không. Ngoài ra nếu tạm nới bớt những định kiến hay tư tưởng về đạo đức của xã hội thì nó cũng có thể giúp cho người phụ nữ có thể mang thai và có con ở độ tuổi lớn hơn độ tuổi được khuyến nghị (hiện tại thường phụ nữ sẽ được khuyến nghị nên mang thai và có con trước 35 tuổi). Thêm nữa ý tưởng tạo trứng với tinh trùng theo dạng này cũng được kỳ vọng giúp đảo ngược tình trạng suy giảm dân số do người dân ngại sinh nở như hiện tại.

IVG, In-vitro gametogenesis, là phương pháp giúp tái lập trình di truyền của các tế bào da hoặc tế bào máu trở thành dạng tế bào gốc, là thứ có thể từ đó trở thành bất cứ các dạng tế bào nào trong quá trình phát triển. Tiếp đó họ sẽ xử lý để từ tế bào gốc qua các bước tác động phát triển thành tinh trùng hoặc trứng. Và tiếp đó là làm các bước của thụ tinh ống nghiệm để có thể bắt đầu quá trình mang thai.
Vấn đề lớn nhất của công nghệ này đó là tính đạo đức của nó. Nhiều quốc gia xác định cấm việc dùng tế bào được tạo ra trong phòng thì nghiệm trong các biện pháp hỗ trợ sinh sản. Cùng với đó những ví dụ của ý tưởng đem tế bào của 1 người nuôi cấy thành trứng và tinh trùng rồi cho thụ thai, hay ý tưởng dùng tế bào của 2 người đồng giới “biến hóa” nó thành trứng và tinh trùng để sinh ra 1 em bé hiện vẫn đang còn quá nhạy cảm. Vậy nên về mặt công nghệ thì có thể thực hiện được, chỉ là từ có thể đến thành hiện thực thì có làm được không mà thôi.
Tham khảo The Guardian